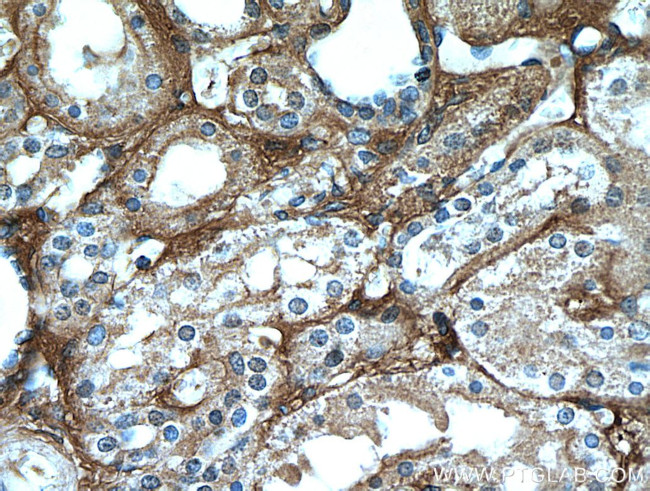
Fibrinogen beta chain Antibody in Immunohistochemistry (Paraffin) (IHC (P))
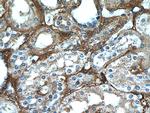
Fibrinogen beta chain Antibody in Immunohistochemistry (Paraffin) (IHC (P))

Search
Proteintech
Fibrinogen beta chain Polyclonal Antibody
{{$productOrderCtrl.translations['antibody.pdp.commerceCard.promotion.promotions']}}
{{$productOrderCtrl.translations['antibody.pdp.commerceCard.promotion.viewpromo']}}
{{$productOrderCtrl.translations['antibody.pdp.commerceCard.promotion.promocode']}}: {{promo.promoCode}} {{promo.promoTitle}} {{promo.promoDescription}}. {{$productOrderCtrl.translations['antibody.pdp.commerceCard.promotion.learnmore']}}
产品信息
16747-1-AP
种属反应
已发表种属
宿主/亚型
分类
类型
抗原
偶联物
形式
浓度
规格
纯化类型
保存液
内含物
保存条件
运输条件
产品详细信息
Immunogen sequence: SSSFQYMYL LKDLWQKRQK QVKDNENVVN EYSSELEKHQ LYIDETVNSN IPTNLRVLRS ILENLRSKIQ KLESDVSAQM EYCRTPCTVS CNIPVVSGKE CEEITRKGGE TSEMYLIQPD SSVKPYRVYC DMNTENGGWT VIQNRQDGSV DFGRKWDPYK QGFGNVATNT DGKNYCGLPG EYWLGNDKIS QLTRMGPTEL LIEMEDWKGD KVKAHYGGFT VQNEANKYQI SVNKYRGTAG NALMDGASQL MGENRTMTIH NGMFFSTYDR DNDGWLTSDP RKQCSKEDGG GWWYNRCHAA NPNGRYYWGG QYTWDMAKHG TDDGVVWMNW KGSWYSMRKM SMKIRPFFPQ Q (142-491 aa encoded by BC107766)
靶标信息
FIBB is the beta component of fibrinogen, a blood-borne glycoprotein comprised of three pairs of nonidentical polypeptide chains. Following vascular injury, fibrinogen is cleaved by thrombin to form fibrin which is the most abundant component of blood clots. In addition, various cleavage products of fibrinogen and fibrin regulate cell adhesion and spreading, display vasoconstrictor and chemotactic activities, and are mitogens for several cell types. Mutations in its gene lead to several disorders, including afibrinogenemia, dysfibrinogenemia, hypodysfibrinogenemia and thrombotic tendency.
仅用于科研。不用于诊断过程。未经明确授权不得转售。
生物信息学
蛋白别名: beta-fibrinogen; beta-fibrinogen precursor; epididymis secretory sperm binding protein Li 78p; Fibrinogen beta chain; fibrinogen, B beta polypeptide; fibrinogen, beta polypeptide; Liver regeneration-related protein LRRG036/LRRG043/LRRG189; MGC104327; MGC120405; unnamed protein product
基因别名: 2510049G14Rik; Ab1-181; Ab1-216; Ac1-581; FGB; HEL-S-78p
UniProt ID: (Human) P02675, (Rat) P14480, (Mouse) Q8K0E8
Entrez Gene ID: (Human) 2244, (Rat) 24366, (Mouse) 110135